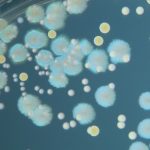
Bilim İnsanları En Düşük Gen Miktarına Sahip Canlı Bir Hücre Üretmeyi Başardı!

Ana Sayfa Ara
evrim - arama sonuçları
Aradığını bulamadıysan, yeni bir arama yap
DNA Dizilimi Nasıl Yapılır?
DNA'yı dizilemek çok ama çok basittir: Bir molekül vardır, ona bakarsınız ve bulduğunuzu kağıda yazarsınız. Bunun kolay olduğunu düşündünüz, ki zaten öyle. Sorun, bir...
Bilim İnsanları En Düşük Gen Miktarına Sahip Canlı Bir Hücre Üretmeyi Başardı!
İnsanların yaklaşık 20.000'e yakın geni vardır ve bilim insanları bunların çoğunun işlevini henüz bilmiyor. Bilimsel deneylerde kullanılan bakterilerin bile 4.000-5.000 arasında geni bulunur. Eğer...
Bakterilerin ‘Biyolojik Tekerlekleri’ Üç Boyutlu Olarak Görüntülendi!
Bakterilerin bir çok yeteneği mevcut fakat bunlar arasında belki de ünü en az olanı hücreye ait özel bir bölge olan ve bakterilerin hareketini sağlayan...
Dev Virüslerin de Bağışıklık Sistemi Var!
Bakteriler gibi büyük virüslerin de kendilerini dış güçlerden koruması gerekir. Bunu en iyi yerine getirecek şey ise bir bağışıklık sistemidir. Nature dergisinde yayımlanan bir araştırmaya göre büyük...
Kök Hücrelerden Sperm Üretmek Mümkün Olabilir!
İnsandan fareye her memeli, üreme hücrelerinin birleşimine dayanan eşeyli üreme yöntemi ile nesillerini devam ettirir. Ancak bu birleşmeye gelene kadar erkek ve kadın üreme...